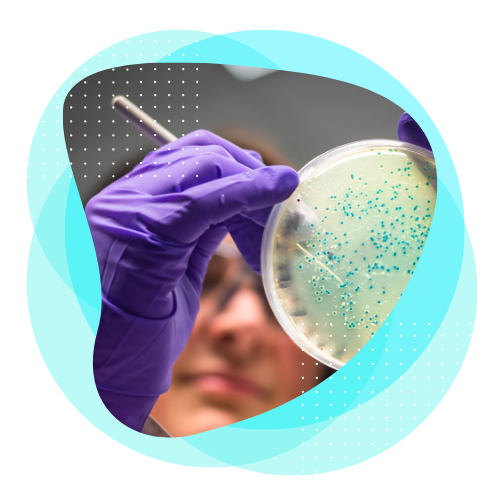
image-header-sci

Get notified on new marketing insights
Here mention the benefits of subscribing
Resource Hub
Learn how Signant's evidence generation solutions and thought leadership advance clinical development
CONTENT TYPE
Apr 3, 2026
Mar 13, 2026
Feb 5, 2026
Jan 26, 2026
Jan 26, 2026
Dec 8, 2025
Nov 7, 2025
Oct 30, 2025
Oct 29, 2025
Oct 29, 2025
Oct 27, 2025
Oct 23, 2025
Oct 8, 2025
Sep 25, 2025
Sep 19, 2025
Aug 21, 2025
Aug 21, 2025
Aug 21, 2025
Aug 21, 2025
Aug 21, 2025
Aug 21, 2025
Aug 21, 2025
Aug 21, 2025
Aug 21, 2025
Aug 21, 2025
Aug 20, 2025
Aug 15, 2025
Aug 6, 2025
Aug 6, 2025
Jul 11, 2025
Jul 11, 2025
Jul 11, 2025
Jul 11, 2025
Jul 11, 2025
Jul 11, 2025
Jun 3, 2025
Jun 3, 2025
Jun 3, 2025
May 29, 2025
Brochure
Rater Training for Clinical Trials
May 29, 2025
Brochure
Unified Platform Overview
May 29, 2025
Brochure
EDC Platform Overview
May 29, 2025
Brochure
Rater Station Overview
May 29, 2025
Brochure
eCOA Platform Overview
May 29, 2025
Brochure
CDR System Overview
May 29, 2025
May 29, 2025
Brochure
Randomization & Supply Management
May 29, 2025
May 29, 2025
Brochure
Telemedicine for Clinical Trials
May 29, 2025
Brochure
eConsent Platform Overview
May 29, 2025
Brochure
Clinical Data Hub Overview
May 29, 2025
Brochure
PureSignal Analytics Overview
May 29, 2025
May 29, 2025
Brochure
Solutions for CROs
May 29, 2025
May 29, 2025
Brochure
Medical Device Trials
May 28, 2025
Brochure
Phase I Studies
May 28, 2025
May 28, 2025
Apr 25, 2025
Jan 21, 2025
Jan 21, 2025
Jan 21, 2025
Jan 21, 2025
Jan 21, 2025
Jan 20, 2025
Nov 19, 2024
Nov 13, 2024
Nov 7, 2024
Oct 14, 2024
Oct 11, 2024
Oct 4, 2024
Brochure
Signant Health Company Overview
Oct 3, 2024
Sep 24, 2024
Jun 14, 2024
Jun 11, 2024
May 6, 2024
May 5, 2024
Brochure
Optimizing RSV Vaccine Trials
Mar 14, 2024
Mar 12, 2024
Feb 20, 2024
Feb 8, 2024
Nov 15, 2023
Case Study
Managing Complex Dosing Schemes with RTSM
Nov 6, 2023
Sep 28, 2023
Sep 27, 2023
Sep 20, 2023
Sep 14, 2023
Jul 19, 2023
Jul 12, 2023
Jul 11, 2023
Jul 10, 2023
Jul 7, 2023
Brochure
Psychedelics Solutions
Jun 23, 2023
May 23, 2023
May 11, 2023
May 11, 2023
May 8, 2023
May 8, 2023
May 8, 2023
May 5, 2023
May 4, 2023
May 3, 2023
May 2, 2023
Apr 12, 2023
Mar 7, 2023
Mar 6, 2023
White paper
Computerized Adaptive Tests Using PROMIS CAT
Feb 24, 2023
Feb 1, 2023
Feb 1, 2023
Jan 30, 2023
Jan 25, 2023
Jan 17, 2023
Jan 12, 2023
Jan 10, 2023
Dec 13, 2022
Nov 17, 2022
Oct 26, 2022
Oct 24, 2022
Oct 6, 2022
Sep 21, 2022
Sep 12, 2022
Sep 9, 2022
Case Study
Flexible RTSM Enables Mid-Study Switch to Direct-to-Patient Dispensation in Immunology Trial
Sep 7, 2022
Jun 30, 2022
Jun 29, 2022
Jun 14, 2022
Jun 2, 2022
Jun 1, 2022
May 24, 2022
May 5, 2022
Apr 27, 2022
White paper
Site Perspectives on BYOD ePRO Use
Apr 18, 2022
Apr 12, 2022
Apr 5, 2022
Mar 17, 2022
White paper
Four Components of eCOA Success
Mar 2, 2022
Feb 28, 2022
Feb 16, 2022
Feb 1, 2022
Jan 20, 2022
Jan 20, 2022
Jan 9, 2022
White paper
Managing the Data Explosion in Clinical Trials
Dec 16, 2021
Dec 14, 2021
Dec 8, 2021
Nov 15, 2021
Nov 2, 2021
Sep 26, 2021
Case Study
Facilitating COVID-19 Vaccine Trial Success
Sep 21, 2021
Sep 15, 2021
Sep 10, 2021
Sep 8, 2021
Aug 10, 2021
Jul 25, 2021
Jul 23, 2021
Jul 1, 2021
Jul 1, 2021
Jun 17, 2021
Jun 16, 2021
Jun 8, 2021
Jun 1, 2021
May 20, 2021
May 3, 2021
Apr 19, 2021
Feb 15, 2021
Feb 3, 2021
Dec 4, 2020
Oct 7, 2020
Oct 1, 2020
Aug 20, 2020
Aug 11, 2020
Aug 10, 2020
Jul 7, 2020
Jun 9, 2020
Jun 9, 2020
May 8, 2020
White paper
Remote Ratings as an Adaptation to COVID-19
May 8, 2020
May 6, 2020
May 5, 2020
May 5, 2020
May 5, 2020
May 5, 2020
May 5, 2020
May 1, 2020
Apr 1, 2020
Mar 2, 2020
Mar 1, 2020
Feb 21, 2020
Feb 3, 2020
Feb 1, 2020
Jan 1, 2020
Sep 17, 2019
Jul 1, 2019
May 9, 2019
Mar 1, 2019